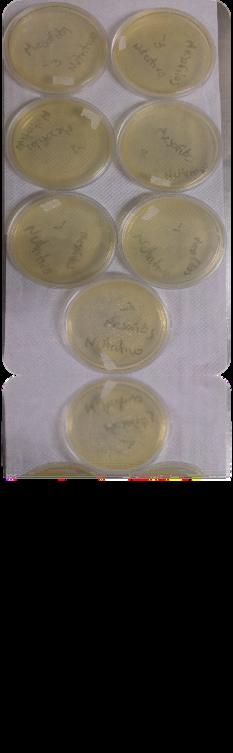

INTRODUCCIÓN
ANTECEDENTES
METODOLOGÍAEXPERIMENTAL
ACTIVIDADESPRELIMINARES
OBJETIVOPARTICULAR1
OBJETIVOPARTICULAR2
OBJETIVOPARTICULAR3
OBJETIVOPARTICULAR4
OBJETIVOPARTICULAR5
OBJETIVOPARTICULAR6
OBJETIVOPARTICULAR7
RESULTADOSYANÁLISISDERESULTADOS
OBJETIVOPARTICULAR1 11 ESTUDIODEMERCADO
OBJETIVOPARTICULAR2
22 EVALUACIÓNSENSORIALDEPROTOTIPOSDELABASE DELATARTALETA
23 DIFERENCIATOTALDECOLOR
OBJETIVOPARTICULAR3
32 EVALUACIÓNSENSORIALDEPROTOTIPOSDEL RELLENODELATARTALETA
OBJETIVOPARTICULAR4
41ANÁLISISQUÍMICOPROXIMALDELATARTALETA
42INFORMACIÓNNUTRIMENTAL
OBJETIVOPARTICULAR5
51ANÁLISISMICROBIOLÓGICO
OBJETIVOPARTICULAR6
61 EVALUACIÓNSENSORIALALATARTALETACON RELLENO,BAJASENAZÚCAR
OBJETIVOPARTICULAR7
DISEÑODELAETIQUETAYENVASE

BALANCEDECOSTOS
CONCLUSIONES
RECOMENDACIONES REFERENCIAS

•El polvo de jamaica y la chía reportaron valores similares en el contenido de fibra cruda a los reportados bibliográficamente. Además, se obtuvo un rendimiento del 60% del polvo de jamaica.
•El estudio de mercado indicó que la propuesta de las tartaletas tendría gran aceptación por ser nutritivo y novedoso, identificando como sector consumidor a las personas que oscilan entre los 19-29 años.
•Los cálices de jamaica pasaron de una coloración violeta oscuro a un magenta del polvo de jamaica.
•En la selección de la base de tartaleta, el atributo sensorial con mayor significancia fue el color. En el relleno de mermelada de la tartaleta, los atributos sensoriales de mayor importancia fueron la textura y el sabor.




•La tartaleta proporciona un menor aporte energético y carbohidratos, mayor contenido de fibra cruda (4.07%), por lo que se corrobora como alimento funcional.
•Las tartaletas con relleno redujeron 85.51% el radical DPPH, derivado a su alto contenido de antocianinas. El contenido de fenoles permaneció en un 73.73% con respecto al polvo de jamaica por efecto de la temperatura y pH.
•Las tartaletas son aptas para consumo humano respecto a la calidad higiénica.
•Existe gran aceptabilidad de las tartaletas entre los consumidores, siendo así un producto competitivo. El diseño de la etiqueta y el envase cumplieron con las características y propiedades de la tartaleta, manteniendo un precio comercial entre $25-$35 por una presentación en bolsa de 120 g.
•Estimar la vida útil para determinar el tiempo en que éste mantiene su calidad adecuada.
•Realizar un estudio de identificación de antocianinas totales y compuestos fenólicos a la tartaleta desarrollada para encontrar los componentes bioactivos de mayor importancia.

•Proponer el desarrollo de más productos a base de los cálices de jamaica producida en México, así como su estudio de componentes para contrarrestar ciertos problemas existentes de salud.
•Diseñar y elegir el material adecuado para el embalaje de las tartaletas.
•Realizar un análisis de costos completo, considerando aspectos como proyecciones de producción, almacenamiento, transporte, gastos de publicidad y promoción, etc.



•Alarcón, GA, Buitrago, HD, Romero, FL, Sánchez, LA, Onatra, HW, Ríos, M (2013) Efecto de la avena y/o Lovastatina sobre el perfil lipídico en pacientes dislipedémicos del hospital de Tunjuelito, Bogotá En Revista UDCA Actualidad y Divulgación científica, 16(2): 319-326
•Aranceta, Bartrina, J , Pérez, RC (2006) Frutas, verduras y salud España, Elsevier Masson
•Ariza-Flores R, Serrano-Altamirano V, Navarro-Galindo S, Ovando-Cruz M, Vázquez-Garcia E, Barrios-Ayala A, Michel-Aceves A, Guzmán-Maldonado S y Otero Sánchez M A, (2014) Variedades mexicanas de jamaica (Hibiscussabdariffa L) “Alma blanca” y “Rosalíz” de color claro, y “Cotzaltzin y “Tecoanapa” de color rojo Rev Fitotec Mex Vol 37 (2): 181 – 185
•Baca Urbina, G 2001 Evaluación de Proyectos, 4ta Ed McGraw-Hill
•Baduí, DS (2006) Química de los alimentos 3a ed, México, Pearson Educación
•Borrego, Diego (2009) “¿Qué son las 4Ps?” Marketing para Pymes Recuperado el 10 de febrero de 2018 en http://wwwherramientasparapymescom/que-son-las-4p
•Brand, Williams W, Cuvelier, ME, Berset C (1995) Use of a free radical method to evaluate antioxidant activity En Lebensm Wiss Technol, Vol 28 (1):25-30
•Bueno M, Di Sapio O, Barolo M, et al (2010) Análisis de la calidad de los frutos de Salvia hispanica L (Lamiaceae) comercializados en la ciudad de Rosario (Santa Fe, Argentina) En Boletín Latinoamericano y del Caribe de Plantas Medicinales y Aromáticas, 9 (3): 221-227
•Cabezas-Zabala C, Hernández-Torres B y Vargas-Zárate M, (2016) Azúcares adicionados a los alimentos: efectos en la salud y regulación mundial Revisión literaria Rev Fac Med 2016 Vol 64 No 2: 319-29
•Castañeda, SA, y Guerrero, BJ (2015) Pigmentos en frutas y hortalizas rojas: antocianinas En Temas Selectos de Ingeniería en Alimentos, Vol 9: 25-33
•Cevallos, Mina, Mirna G (2015) Procesamiento de la flor de Jamaica (Hibiscus Sabdariffa) desecado para la preparación de yogurt y bebida con altas propiedades nutracéuticas Tesis de Licenciatura, Universidad de Guayaquil, Ecuador

•Cid-Ortega, S y Guerrero-Beltrán, J A (2012) Propiedades funcionales de la Jamaica (Hibiscus sabdariffa L) Temas Selectos de Ingeniería de Alimentos 6-2: 47-63
•Cofepris (2015) Manual de etiquetado frontal nutrimental Recuperado el 16 de agosto de 2018 en http://wwwcofeprisgobmx/AS/Documents/COMISI%C3%93N%20DE%20OPERACI%C3%93N%20SANITARIA Documentos%20para%20publi car%20en%20la%20secci%C3%B3n%20de%20MEDICAMENTOS/ALIMENTOS/ManualEtiquetado VFpdf
•Coronado, Parra A, Hernández, Hernández JE, Camacho, Tamayo JH (2008) Estudio fisiológico poscosecha y evaluación de la calidad de la ciruela variedad Horvin (prunus domestica l) bajo tres condiciones de almacenamiento refrigerado En Revista Ingeniería e investigación, Vol 28 (1): 99-104
•Coronado, Trinidad M e Hilario, Rosales R (2001) Elaboración de mermeladas: Procesamiento de alimentos para pequeñas y micro empresas agroindustriales Perú, CIED
•Cruz Reyes, Epifania (2015) “Las 4Ps de la mercadotecnia” Emprendices Recuperado el 10 de febrero de 2018 en https://wwwemprendicesco/las-4-ps-la-mercadotecnia/
•Dios-López A, Montalvo-González E, Andrade-González I, Gómez-Leyva J F, (2011) Inducción de antocianinas y compuestos fenólicos en culativos celulares de jamaica (Hibiscus sabdariffa L) in vitro Revista Chapingo Serie Horticultura 17 (2): 77-87


•Diseño de experimentos Estrategias y Análisis en Ciencias e Ingeniería Alfaomega, México
•Domínguez y Domínguez, Jorge; Castaño Tostado, Eduardo (2016)
•Espinosa, Manfugás J (2007) Evaluación sensorial Cuba, Editorial Universitaria
•FAO (2010) Capítulo 16: Análisis de fibra dietética Recuperado el 11 de julio del 2018 en http://wwwfaoorg/docrep/010/ah833s/Ah833s18htm
•Fischer de la Vega, Laura Estela, Espejo Callado, Jorge (2011) “Mercadotecnia” , 4ª Ed McGraw-Hill Hispanoamericana, México
•Fuentes-Berrio, Lorenzo. Acevedo-Correa, Diofanor. Gelvez-Ordoñez, Victor Manuel, 2015. Alimentos funcionales: impacto y retos para el desarrollo y bienestar de la sociedad colombiana Biotecnología en el Sector Agropecuario y Agroindustrial, Vol 13, No 2, Julio – Diciembre Universidad de Cartagena, Colombia:140-149
•Galicia-Flores L A, Salinas-Moreno Y, Espinoza-Garcia B M, Sanchez-Feria C, (2008) Caracterizaci+on fisicoquímica y actividad antioxidante de extractos de jamaica (HibiscusSabdariffa L) nacional e importada Revista Chapingo Serie hoticultura, 14(2): 121-129
•Gutiérrez Tolentino R, Ramírez Vega ML, et al (2014) Contenido de ácidos grasos en semillas de chía (Salvia hispánica L) cultivadas en cuatro estados de México Revista Cubana de Plantas Medicinales, México, 19 (1): 99-207
•Hevia, F, Mellado, M, Wilckens, R, Berti, M, Jofré, S (2003) Rendimiento de harina y aptitud panadera de seis cultivares de trigo de primavera sembrado en tres ambientes En Agrosur, Vol 31 (2): 38-46
•Ibáñez, MF, Barcina, AY (2001) Análisis sensorial de alimentos: métodos y aplicaciones España
•INEGI (2007) Consulta de especies y productos vegetales: Avena Recuperado el 20 de febrero de 2018 en: http://www3inegiorgmx/sistemas/CEPAFOP/view/vDataaspx?op=0&subOp=0&c=11639&s=est
•Jiménez, MF, Cárdenas, JD, Aponte, AA, Restrepo, J (2014) Alternativa de secado de flor de jamaica (Hibiscus sabdariffa L) mediante ventana de refractancia y aire caliente En Revista de la Facultad Nacional Agroalimentaria, Vol 67 (2): 40-45
•Jiménez, P P, Masson, SL, Quitral, VR (2013) Composición química de semillas de chía, linaza y rosa mosqueta y su aporte en ácidos grasos omega-3 En Revista Chilena de Nutrición, Vol 40 (2): 155-160
•Kirk, RS, Sawyer R (1999) Pearson s composition and analysis of foods, 9 a ed, Addison s- Wesley LingmanInc, Harlow, England
•Larousse (2010) El pequeño Larousse Gastronomique en español 3a ed, México
•López, AD, Montalvo, GE, González, IA, Gómez, LJ (2011) Inducción de antocianinas y compuestos fenólicos en cultivos celulares de jamaica (Hibiscussabdariffa L) in vitro En Revista Chapingo serie Horticultura, 17(2): 77-87
•Luján Austreberta (2005) Beneficios de la flor de jamaica (Hibiscussabdariffa L) Revista vinculando, México: 1-3
••Luna, P, Lopes A, Sammán, N, et al (2013) Evaluación de la harina entera de chía (Salvia hispanica L) y grasa vegetal hidrogenada en pastel Food Science and Technology, Vol 54 (1): 73-79
•Macías, S, Binaghi, MJ, Zuleta, A, Ronayne de Ferrer, P, Costa, K, Generoso, S (2013) Desarrollo de galletas con sustitución parcial de harina de trigo con harina de algarroba (Prosopis alba) y avena para planes sociales En Revista Venezolana de Ciencia y Tecnología de Alimentos, Vol 4(2), ISSN: 2218-4384: 179-180
•Mellado, M M S, Haros, M (2016) Evaluación de la calidad tecnológica, nutricional y sensorial de productos de panadería por sustitución de harina de trigo por harina integral de arroz En Brazilian Journal of Food Technology, Vol 19: 1-9
•Moreiras O, Carbajal A, Cabrera L, Cuadrado C (2013) Tablas de composición de alimentos 16° ed, España, Pirámide
•Moreno Manuel G y Alarcón Alejandra (2010) Higiene alimentaria para la prevención de trastornos digestivos infecciosos por toxinas Revista Médica Clínica Las Condes, Vol 21:749-55
•NMX-F-006-1983 Alimentos Galletas Food Cookie Normas mexicanas Dirección General de Normas
•NMX-F-066-S-1978 Determinación de cenizas en alimentos Foodstuff determination of ashes Normas mexicans Dirección General de Normas
•NMX-F-083-1986 Alimentos Determinación de humedad en productos alimenticios Foods Moisture in food products determination Normas mexicanas Dirección General de Normas
•NMX-F-090-S-1978 Determinación de fibra cruda en alimentos Foodstuff determination of crude fibre Normas mexicanas Dirección General de Normas
•NMX-F-317-S-1978 Determinación de pH en alimentos Determination of pH in foods Normas mexicanas Dirección General de Normas
•NMX-F-516-1992 Alimentos Productos de panificación Clasificación y definiciones Foods Bakery products Definitions and clasification Normas mexicanas Dirección General de Normas
•Norma CODEX Para las confituras, jaleas y mermeladas (CODEX STAN 296-2009)
•NMX-FF-115-SCFI-2010 Productos agrícolas destinados para consumo humano Flor (cáliz) de jamaica (Hibiscussabdariffa L), especificaciones y métodos de prueba
•NORMA Oficial Mexicana NOM-051-SCFI/SSA1-2010, Especificaciones generales de etiquetado para alimentos y bebidas no alcohólicas preenvasados-Información comercial y sanitaria
•NORMA Oficial Mexicana NOM-086-SSA1-1994, Bienes y servicios Alimentos y bebidas no alcohólicas con modificaciones en su composición Especificaciones nutrimentales
•NORMA Oficial Mexicana NOM-092-SSA1-1994, Bienes y servicios Método para la cuenta de bacterias aerobias en placa

•NORMA Oficial Mexicana NOM-111-SSA1-1994, Bienes y servicios Método para la cuenta de mohos y levaduras en alimentos
•NORMA Oficial Mexicana NOM-113-SSA1-1994, Bienes y servicios. Método para la cuenta de microorganismos coliformes totales en placa.
•OCDE, Health at a Glance 2017: OECD Indicators ¿Cómo se compara México? Recuperado el 24 de febrero del 2018 en https://wwwoecdorg/mexico/Health-at-a-Glance-2017-Key-Findings-MEXICO-in-Spanishpdf
•Orjuela Córdova, Soledad & Sandoval Medina, Paulina (2002) “Guía del estudio de mercado para la evaluación de proyectos” , seminario Universidad de Chile, Santiago, 145 pp
•Ortega, M, Barboza, Y, Piñero, MP, Parra, K (2016)Formulación y evaluación de una galleta elaborada con avena, linaza y pseudofruto de caujil como alternativa de un alimento funcional En Multiciencias, Vol 16 (1): 76-86
•Ortiz-Márquez, S (2008) Composición en macronutrientes, minerales y metales pesados en cálices de jamaica cultivada en el estado Monagas Tecnología y pensamiento, 3 (1-2): 61-75
•PRODAR Manual de Procesos Agroindustriales Proyecto de Capacitación para el Fomento de la Agroindustria Rural Instituto Interamericano de Cooperación para la Agricultura San José – Costa Rica Documento sin publicar 120 p
•Reyes, Luengas A, Salinas, Moreno Y, Ovando, Cruz ME, Arteaga, Garibay RI, Martínez, Peña D (2015) Análisis de ácidos fenólicos y actividad antioxidante de extractos acuososos de variedades de jamaica (Hibiscussabdariffa L) con cálices de colores diversos En revista Agrociencia, Vol 49: 277-290
•R Lees (1982) Análisis de los alimentos: métodos analíticos y de control de calidad (2a ed), España, ACRIBIA
•SAGARPA (2017) Producción Agrícola Servicio de Formación Agroalimentaria y Pesquera (SIAP) Recuperado el 26 de Febrero del 2018 en http:/ /wwwsagarpagobmx
•Salinas-Moreno, Yolanda, Zúñiga-Hernández, Araceli Rosa Elena, Jiménez-De la Torre, Luis Bartolomé, Serrano-Altamirano, Víctor, & SánchezFeria, César (2012) Color en cálices de jamaica (Hibiscussabdariffa L) y su relación con características fisioquímicas de sus extractos acuosos Revista Chapingo Serie horticultura, 18(3): 395-407
•Sancho, VJ, Bota, E, Castro, JJ (1999) Introducción al análisis sensorial de los alimentos España, Universidad de Barcelona
•Sarmiento Rubiano, LA, (2006) Alimentos funcionales, una nueva alternativa de alimentación Revista Orinoquia, vol 10 (1) Universidad de Los Llanos Meta, Colombia pp 16-23
•Simopoulos, AP, Cleland, LG (2003) Omega-6 / omega-3 proporción de ácidos grasos esenciales: la evidencia científica World Review of Nutrition and Dietetics, Vol 92: 1-13
•Sumaya, M.M.T., Medina, C.R., Machuca, S.M., Jiménez R.E., Balois, M.R., Sánchez, H.L. (2014). Potencial de la jamaica (Hibiscus sabdariffa L.) en la elaboración de alimentos funcionales con actividad antioxidante En Revista Mexica de Agronegocios, Vol 3: 1082-1088


•Xingú, López A, González, Huerta A, De la Cruz, Torrez E, Sangerman, Jarquín D, Orozco, de Rosas G, Rubí , Arriaga M (2017) Chía (Salvia hispanica L) situación actual y tendencias futuras En revista Mexicana de Ciencias Agrícolas, Vol 8 (7), 1619-1631
•Yilmaz, Y, y Toledo, R (2005) Antioxidant activity of water-soluble Maillard reaction products En Food Chemistry, Vol 5 (3): 273-278
• Zambrano, R, Granito, M, Valero, y (2013) Respuesta glucémica al consumo de una barra de cereales-leguminosas (Phaseolus vulgaris) en individuos sanos En Archivos Latinoamericanos de Nutrición, Vol 6 (2): 134-141



